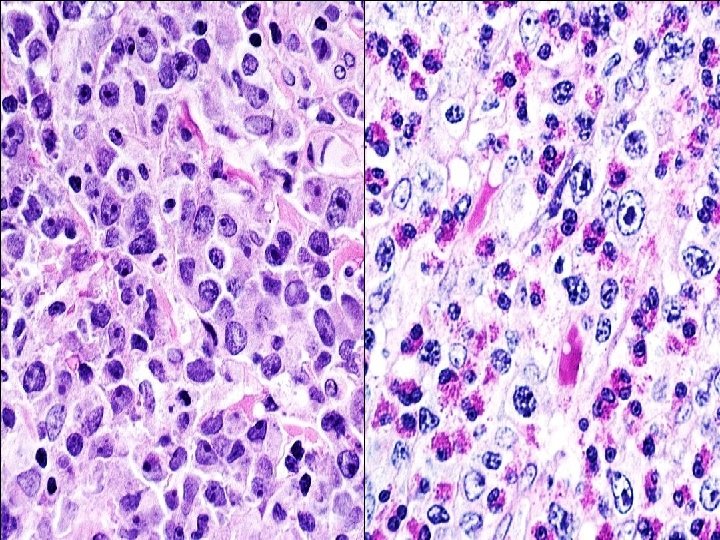

Case 17 d male was diagnosed with gluten

- Slides: 20
Case 17 d male was diagnosed with gluten • A 68 -year-old o -sensitive enteropathy five years earlier. He was managed on a gluten free diet. Four years later he presented with severe small bowel obstruction localized to distal ileum. He underwent small bowel resection.
CD 3+ CD 103+
CD 5 CD 8
TIA-1 CD 30
ALK-1
Case 17 • Diagnosis: Enteropathy-associated T-cell lymphoma, ALK-positive, with features of anaplastic large cell lymphoma • ALK translocation (variant) was confirmed by FISH • Clinical history favors EATL • CD 30 weaker than usually seen in ALCL • Mneimneh WS et al. Enteropathy-associated anaplastic large T cell lymphoma ALK-positive (EA-ALCL-ALK+): variant of T cell lymphoma with possible two-hit pathogenesis. J Hematopathol in press
Enteropathy-associated T-Cell Lymphoma • Associated with celiac disease – 95% of patients have HLA-DQ 2 encoded by HLA DQA 1 0501, DQB 1 0201 • Gluten-free diet may reduce risk • In some patients, lymphoma may be the presenting feature
Celiac Disease Icebergs F. A. Hamilton, NIDDK Overall Diagnosed Ireland Italy Netherlands Sweden USA
Enteropathy Associated T-cell Lymphoma (EATL) I • Broad morphological spectrum Adjacent mucosa shows villous atrophy • CD 3+, CD 103+, Cytotoxic markers, TCR ab often double negative for CD 4/CD 8, CD 56 • Often presents with intestinal perforation aggressive clinical course with poor prognosis
CD 30
Monomorphic type (Type II) • Medium sized cells with clear cytoplasm • CD 56 +, CD 8+, CD 4 • 8 q 24 (myc) amplifications • May occur sporadically, without celiac disease • Most likely an independent entity, but In WHO 2008 still included as subtype of EATL
EATL in Hong Kong Chan et al. AJSP 2011 • • • 18 cases – all EATL Type II (monomorphic) 13 males/ 5 females Median age: 62 No history of malabsorption All EBV negative 14 (78%) gamma delta 6 (33%) alpha beta – 3 cases dual positive, 1 case TCR silent
Intestinal T-cell Lymphomas. Summary • EATL II (monomorphic type) – is a separate disease from classical EATL, I associated with celiac disease • Other T-cell or NK-cell lymphomas can present with intestinal disease – Gamma-delta TCL, some resembling EATL II – Nasal type T/NK-cell lymphoma – Anaplastic large cell lymphoma • All may present as “intestinal T-cell lymphomas”